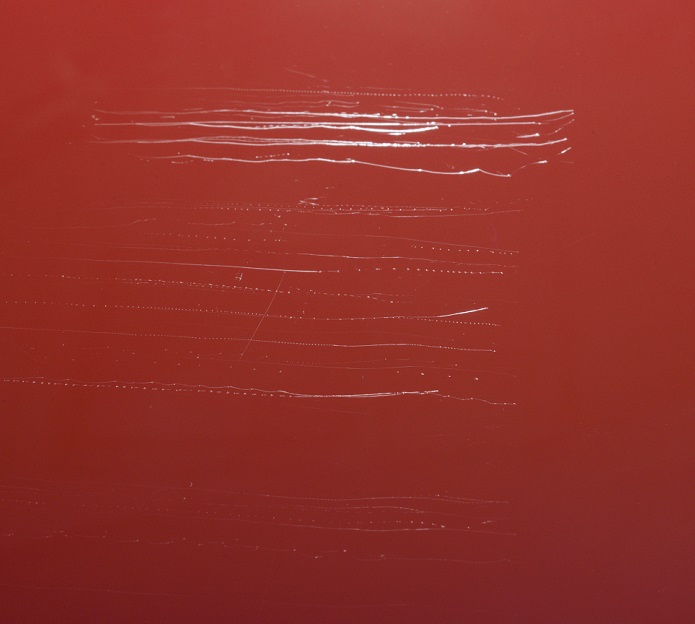
krok 1

| Doprava ZDARMA pri nákupe nad 100 € |
Kategórie
Prihlásenie
Najpredávanejšie
- 01.MENZERNA One-Step 3 IN 1 - Jednokroková leštiaca pasta 250 ml
- 02.MENZERNA 400 Heavy Cut - Brúsna pasta 250 ml
- 03.MENZERNA Heavy Cut 1000 - Leštiaca pasta 250 ml
- 04.MENZERNA Medium Cut 2500 - Leštiaca pasta 250 ml
- 05.MENZERNA Super Finish Plus 3800 - Leštiaca pasta 250 ml
- 06.MENZERNA Final Finish 3000 - Leštiaca pasta 250 ml
- 07.MENZERNA Medium Cut 2000 - Leštiaca pasta 250 ml
- 08.MENZERNA Cut Force Pro - Leštiaca pasta 20 ml
- 09.SIA SIAWAT Vodný brúsny papier 230 x 280 mm P600
- 10.MENZERNA 2400 Medium Cut - Leštiaca pasta 250 ml
Novinky
Blog / Články
Aké pasty zvoliť pre čo najlepší a najrýchlejší výsledok
Úvod
Postupnosť leštenia
Postupnosť leštenia
![]() |
||
Krok 1 Brúsne pasty |
||
| Brúsne pasty Menzerna spoľahlivo, rýchlo a dôkladne odstraňujú hlboké škrabance, poprach zo striekania a silné známky používania. Ideálne sú aj po brúsení. |
||
300 / 400 / 1000 / CUT FORCE PRO |
||
![]() |
||
Krok 2 Stredné pasty |
||
| Stredné pasty Menzerna odstránia na známky používania a mierne škrabance. Jemné abrazívne pasty pre dosiahnutie povrchu bez škrabancov s výnimočným leskom. |
||
2000 / 2400 / 2500 / 3IN1 |
||
![]() |
||
Krok 3 Dokončovacie pasty |
||
|
Perfektné pasty na drobné škrabance |
||
3000 / 3500 / 3800 |
||
|
|
![]() |
||
Krok 4 Ochranné pasty |
||
| Ponúkajú dlhotrvajúcu ochranu. Pre chránený, viditeľne hladší povrch s perfektnými vlastnosťami odpudzovania vody. |
||
POWER LOCK
|
||
|
|